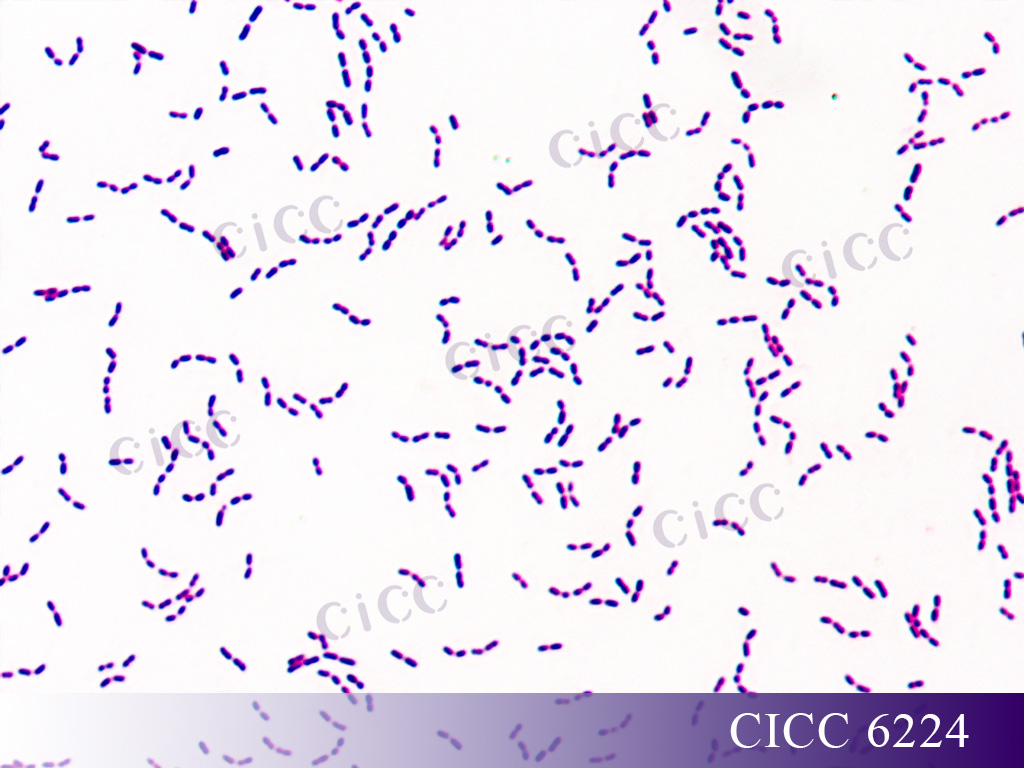
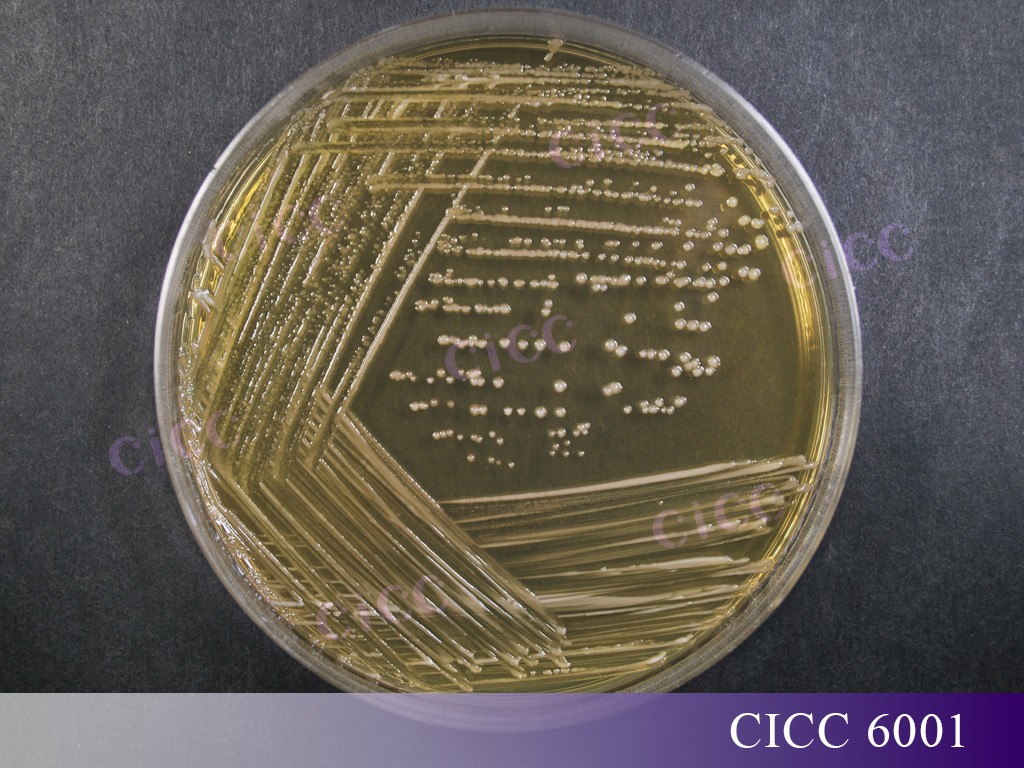

鼠李糖乳酪桿菌:功能多樣的明星益生菌
鼠李糖乳酪桿菌 Lacticaseibacillus rhamnosus
厚壁菌門 Firmicutes
芽孢桿菌綱 Bacilli
乳桿菌目 Lactobacillales
乳桿菌科 Lactobacillaceae
乳酪桿菌屬 Lacticaseibacillus
鼠李糖乳酪桿菌是一種能夠調(diào)節(jié)微生態(tài)平衡、增強(qiáng)宿主腸道抵抗力的益生菌,被廣泛應(yīng)用于嬰幼兒配方食品和各種膳食補(bǔ)充劑中,是現(xiàn)代營養(yǎng)學(xué)和醫(yī)學(xué)領(lǐng)域的研究熱點(diǎn)。目前全球已有40多個國家和地區(qū)有相關(guān)產(chǎn)品生產(chǎn)和銷售,無疑是對該菌應(yīng)用價值的高度肯定。
本文將詳細(xì)介紹鼠李糖乳酪桿菌的研究進(jìn)展,國內(nèi)外保藏情況、特征特性以及乳桿菌的分類學(xué)變遷情況,讓大家對該菌有更深入的了解和認(rèn)識。
一、鼠李糖乳酪桿菌的研究進(jìn)展
鼠李糖乳酪桿菌是目前研究最多的益生菌菌種之一,根據(jù)《2023腸道產(chǎn)業(yè)發(fā)展白皮書》中統(tǒng)計(jì)結(jié)果顯示,累計(jì)研究最多前十株益生菌中,三株來自鼠李糖乳酪桿菌,分別為Lacticaseibacillus rhamnosus GG、Lacticaseibacillus rhamnosus HN001和Lacticaseibacillus rhamnosus GR-1。其中,Lacticaseibacillus rhamnosus GG最早于1985年由Sherwood Gorbach與Barry Goldwin兩位研究者從健康成年人糞便樣本中分離獲得[1],是目前研究最多、最全面的益生菌菌株,累計(jì)發(fā)表研究2000余篇,包括醫(yī)學(xué)循證相關(guān)400余篇。
1. 在腸道疾病方面
炎癥性腸病(IBD)是一種慢性腸道炎癥疾病,其發(fā)病機(jī)制尚不完全清晰,該疾病在西方較為常見,近年來在亞洲的發(fā)病率也逐年提高。研究表明,鼠李糖乳酪桿菌可以通過調(diào)節(jié)IBD患者腸道微生物組成、保護(hù)腸上皮細(xì)胞屏障、調(diào)節(jié)腸炎引起的宿主免疫紊亂、黏附致病菌等方面起到預(yù)防或緩解IBD的作用[2]。如,Lacticaseibacillus rhamnosus SHA113可以通過提高結(jié)腸炎小鼠腸道中產(chǎn)短鏈脂肪酸微生物豐度、下調(diào)炎癥因子濃度和提高緊密連接蛋白表達(dá)量起到治療結(jié)腸炎的作用[3]。
腹瀉是最常見的腸道疾病,細(xì)菌感染、病毒感染和抗生素治療等原因均能引起腹瀉。研究報道,鼠李糖乳酪桿菌可以通過恢復(fù)腸道菌群、干擾輪狀病毒復(fù)制、調(diào)節(jié)免疫細(xì)胞等機(jī)制,緩解腹瀉及腹瀉引起的上皮屏障損傷[4]。其中,Lacticaseibacillus rhamnosus GG(LGG)已廣泛應(yīng)用于兒童腹瀉的輔助治療中,通過對19項(xiàng)LGG治療兒童腹瀉臨床實(shí)驗(yàn)的薈萃分析表明,服用LGG可以縮短腹瀉時間、降低腹瀉頻率并改變糞便稠度[5]。
2. 在代謝疾病方面
許多研究表明,鼠李糖乳酪桿菌可通過調(diào)節(jié)腸道菌群、恢復(fù)腸道屏障功能等方面發(fā)揮緩預(yù)防或治療代謝疾病的作用。如,在高糖飲食誘導(dǎo)的小鼠非酒精性脂肪肝模型中,灌胃Lacticaseibacillus rhamnosus GG可以增加小腸中有益菌的數(shù)量、恢復(fù)十二指腸緊密連接蛋白濃度并降低肝臟中炎癥因子濃度,進(jìn)而起到預(yù)防和保護(hù)的作用[6]。Lacticaseibacillus rhamnosus FJSYC4-1可以通過調(diào)節(jié)腸道菌群、增加短鏈脂肪酸產(chǎn)量并誘導(dǎo)腸道分泌飽腹感激素,進(jìn)而抑制食物攝入,緩解代謝綜合征小鼠血糖紊亂、血脂紊亂和組織損傷的癥狀[7]。
3. 在呼吸道疾病方面
研究表明,鼠李糖乳酪桿菌可以通過腸-肺軸和局部粘膜免疫的方式,起到促進(jìn)呼吸系統(tǒng)健康的作用。鼻腔用Lacticaseibacillus rhamnosus CRL1505通過調(diào)節(jié)呼吸道中Toll樣受體(TLR)-3引起的免疫反應(yīng),提高呼吸道粘膜中白介素10(IL-10)含量,來預(yù)防呼吸道合胞病毒(RSV)感染引起的炎癥損傷,并提高病毒清除率[8]。此外,口服Lacticaseibacillus rhamnosus Lcr35可通過調(diào)節(jié)T細(xì)胞介導(dǎo)免疫反應(yīng)來抑制小鼠過敏性哮喘[9]。
4. 在過敏性疾病方面
特應(yīng)性皮炎(AD)是一種慢性皮膚炎癥疾病,過敏是引起AD的主要原因之一,近年來兒童AD的發(fā)病率逐年提升[10]。一項(xiàng)隨機(jī)、雙盲、對照實(shí)驗(yàn)表明,口服Lacticaseibacillus rhamnosus MP108膠囊可有效緩解兒童AD患者皮膚炎癥面積、皮炎強(qiáng)度并降低特應(yīng)性皮炎疾病評分[11]。另一項(xiàng)臨床實(shí)驗(yàn)表明,對濕疹高危嬰兒在0-2歲補(bǔ)充Lacticaseibacillus rhamnosus HN001可有效降低這些兒童在6歲之前的濕疹患病率、濕疹嚴(yán)重程度和皮膚過敏反應(yīng)[12]。
5. 在女性健康方面
Lacticaseibacillus rhamnosus GR-1是在女性健康領(lǐng)域研究的最多的益生菌[13]。一項(xiàng)隨機(jī)、對照臨床實(shí)驗(yàn)表明,口服含Lacticaseibacillus rhamnosus GR-1的膠囊可以恢復(fù)細(xì)菌感染性陰道菌群,減少潛在致病菌和酵母菌在陰道的定植[14]。另一項(xiàng)隨機(jī)、雙盲、對照實(shí)驗(yàn)表明,口服含Lacticaseibacillus rhamnosus GR-1的膠囊可以顯著提高甲硝銼對細(xì)菌性陰道疾病的治愈率[15]。
二、國內(nèi)外保藏情況
近年來,鼠李糖乳酪桿菌在食品工業(yè)中的應(yīng)用日益增多,如作為功能性乳酸菌添加到酸奶、乳酪等乳制品中。鼠李糖乳酪桿菌在國際各大保藏中心均有保藏,CICC保藏模式菌株編號為CICC 6224,與多家國際知名菌種中心模式菌株等同編號,如:ATCC 7469、DSM 20021、NCTC 12953。CICC還保藏有多種來源、多種用途的鼠李糖乳酪桿菌,可用于研發(fā)功能性乳酸菌菌劑,廣泛應(yīng)用于食品行業(yè)。
● CICC 6001用于乳酸發(fā)酵,作為陽性對照菌株,適用于《GB 4789.35-2010食品安全國家標(biāo)準(zhǔn) 食品微生物檢驗(yàn) 乳酸菌檢驗(yàn)》。有研究表明,在體外條件下,該菌可以提高氧化應(yīng)激狀態(tài)下 Caco-2 細(xì)胞的抗氧化功能[16]。

● CICC 6013可產(chǎn)光學(xué)純度達(dá)95%以上的L-乳酸,能有效提高乳品黏度、抑制酸奶中霉菌生長,并提高發(fā)酵速度[17]。

三、鼠李糖乳酪桿菌特征特性有哪些?
鼠李糖乳酪桿菌呈短桿狀(0.8-1.0x2.0-4.0 μm),單個或成對分布,不運(yùn)動,無芽孢,革蘭氏染色陽性。
在MRS培養(yǎng)基上菌落呈圓形、白色,凸起,表面光滑、濕潤,邊緣整齊。
兼性厭氧細(xì)菌,生長溫度范圍2~53℃,最適溫度一般為30~40℃。
耐酸,最適pH通常為5.5~6.2,一般在pH=5或更低的情況下可生長。
DNA的G+C含量為45~47%。
不分解酪素,但大多數(shù)菌株能產(chǎn)生少量的可溶性氮;不產(chǎn)吲哚和H2S;接觸酶陰性;無細(xì)胞色素,極少數(shù)菌株以假接觸酶分解過氧化物;聯(lián)苯胺反應(yīng)陰性[18]。

知識點(diǎn):乳桿菌分類學(xué)地位的變遷
隨著科學(xué)家們的深入研究與探尋,乳桿菌的分類學(xué)地位經(jīng)歷了多次變遷和重新評估,這些變化有助于我們更好地了解乳桿菌的生物學(xué)特性。
1901年,Beijerinck提出乳桿菌屬。早期的分類學(xué)主要依據(jù)表型特征,如最適生長溫度、同/異型發(fā)酵能力及代謝產(chǎn)物譜等,在此期間,鼠李糖乳酪桿菌曾被歸為干酪乳桿菌的一個亞種[19]。
1983年,基于16S rRNA的系統(tǒng)發(fā)育學(xué)等基因型方法揭示了乳桿菌屬的多樣性,之后,乳桿菌主要采用16S rRNA的基因序列相似性分析作為分類依據(jù),鼠李糖乳酪桿菌被劃分為一個獨(dú)立的種。
2015年以來,多項(xiàng)基于核心基因組系統(tǒng)發(fā)育的大規(guī)模系統(tǒng)發(fā)育分析揭示了乳桿菌屬的分類學(xué)差異[20]。
2020年,來自全球7個國家、12家權(quán)威機(jī)構(gòu)的15位科學(xué)家利用大量已公布的全基因組數(shù)據(jù),通過生物信息學(xué)分析完成了乳桿菌屬的重要分類學(xué)變遷研究,將乳桿菌屬重新劃分為25個屬,其中包括23個新屬,鼠李糖乳酪桿菌由Lactobacillus rhamnosus變遷為Lacticaseibacillus rhamnosus[21]。
2022年,國家衛(wèi)健委發(fā)布關(guān)于《可用于食品的菌種名單》和《可用于嬰幼兒食品的菌種名單》更新公告,將鼠李糖乳桿菌更名為鼠李糖乳酪桿菌。

乳桿菌屬核心基因組系統(tǒng)發(fā)育樹[19]
參考文獻(xiàn):
[1] 張水華,何詢.鼠李糖乳桿菌LGG相關(guān)產(chǎn)品的研究進(jìn)展[J].微生物學(xué)免疫學(xué)進(jìn)展, 2011,39(04):68-72.
[2] GUO H, YU L, TIAN F, et al. The Potential Therapeutic Role of Lactobacillaceae rhamnosus for Treatment of Inflammatory Bowel Disease [J]. Foods, 2023, 12(4): 692.
[3] PANG B, JIN H, LIAO N, et al. Lactobacillus rhamnosus from human breast milk ameliorates ulcerative colitis in mice via gut microbiota modulation [J]. Food & Function, 2021, 12(11): 5171-5186.
[4] VEMURI R, GUNDAMARAJU R, SHINDE T, et al. Therapeutic interventions for gut d-ysbiosis and related disorders in the elderly: antibiotics, probiotics or faecal microbiota transplantation? [J]. Beneficial microbes, 2017, 8(2): 179-192.
[5] LI Y-T, XU H, YE J-Z, et al. Efficacy of Lactobacillus rhamnosus GG in treatment of acute pediatric diarrhea: A systematic review with meta-analysis [J]. World journal of gastroenterology, 2019, 25(33): 4999.
[6] RITZE Y, BáRDOS G, CLAUS A, et al. Lactobacillus rhamnosus GG protects against non-alcoholic fatty liver disease in mice [J]. PloS one, 2014, 9(1): e80169.
[7] ZHENG F, WANG Z, STANTON C, et al. Lactobacillus rhamnosus FJSYC4-1 and Lactobacillus reuteri FGSZY33L6 alleviate metabolic syndrome via gut microbiota regulation [J]. Food & Function, 2021, 12(9): 3919-3930.
[8] KITAZAWA H, VILLENA J. Modulation of respiratory TLR3-anti-viral response by probiotic microorganisms: lessons learned from Lactobacillus rhamnosus CRL1505 [J]. Frontiers in immunology, 2014, 5: 201.
[9] JANG S-O, KIM H-J, KIM Y-J, et al. Asthma prevention by Lactobacillus rhamnosus in a mouse model is associated with CD4+ CD25+ Foxp3+ T cells [J]. Allergy, asthma & immunology research, 2012, 4(3): 150-156.
[10] BOGUNIEWICZ M, LEUNG D Y. Atopic dermatitis: a disease of altered skin barrier and immune dysregulation [J]. Immunological reviews, 2011, 242(1): 233-246.
[11] WU Y-J, WU W-F, HUNG C-W, et al. Evaluation of efficacy and safety of Lactobacillus rhamnosus in children aged 4–48 months with atopic dermatitis: An 8-week, double-blind, randomized, placebo-controlled study [J]. Journal of microbiology, immunology and infection, 2017, 50(5): 684-692.
[12] WICKENS K, STANLEY T, MITCHELL E, et al. Early supplementation with Lactobacillus rhamnosus HN001 reduces eczema prevalence to 6 years: does it also reduce atopic sensitization? [J]. Clinical & Experimental Allergy, 2013, 43(9): 1048-1057.
[13] PETROVA M I, REID G, TER HAAR J A. Lacticaseibacillus rhamnosus GR-1, aka Lactobacillus rhamnosus GR-1: past and future perspectives [J]. Trends in Microbiology, 2021, 29(8): 747-761.
[14] REID G, CHARBONNEAU D, ERB J, et al. Oral use of Lactobacillus rhamnosus GR-1 and L. fermentum RC-14 significantly alters vaginal flora: randomized, placebo-controlled trial in 64 healthy women [J]. FEMS Immunology & Medical Microbiology, 2003, 35(2): 131-134.
[15] ANUKAM K, OSAZUWA E, AHONKHAI I, et al. Augmentation of antimicrobial metronidazole therapy of bacterial vaginosis with oral probiotic Lactobacillus rhamnosus GR-1 and Lactobacillus reuteri RC-14: randomized, double-blind, placebo controlled trial [J]. Microbes and Infection, 2006, 8(6): 1450-4.
[16] 房婷,李響,劉潔等.鼠李糖乳桿菌通過調(diào)節(jié)腸道微生物群緩解造血干細(xì)胞移植后肝臟移植物抗宿主病[J].基礎(chǔ)醫(yī)學(xué)與臨床, 2021, 41(09):1303-1308.DOI:10.16352/j.issn.1001-6325.2021.09.028.
[17] 徐偉, 王鵬, 張興. 微波輻照對干酪乳桿菌高產(chǎn) L-乳酸的誘變效應(yīng)[J]. 輻射研究與輻射工藝學(xué)報, 2007,25(5):316-320.
[18] 陳宇強(qiáng),曾敏,潘麗媚.鼠李糖乳桿菌生物學(xué)特性及功能特性研究進(jìn)展[J].科技信息,2010 (20):357.
[19] H W Doelle. Kinetic characteristics of phosphofructokinase from Lactobacillus casei var. Rhamnosus ATCC 7469 and Lactobacillus plantarum ATCC 14917.Biochim Biophys Acta. 1972 Feb 28;258(2):404-10.
[20] Zheng J, Wittouck S, Salvetti E, et al. A taxonomic note on the genus Lactobacillus: Description of 23 novel genera, emended description of the genus Lactobacillus Beijerinck 1901, and union of Lactobacillaceae and Leuconostocaceae[J]. International journal of systematic and evolutionary microbiology, 2020, 70(4): 2782-2858.
[21] 食品安全標(biāo)準(zhǔn)與監(jiān)測評估司. 可用于食品的菌種名單和可用于嬰幼兒食品的菌種名單[J]. 國家衛(wèi)生健康委, 2020.


